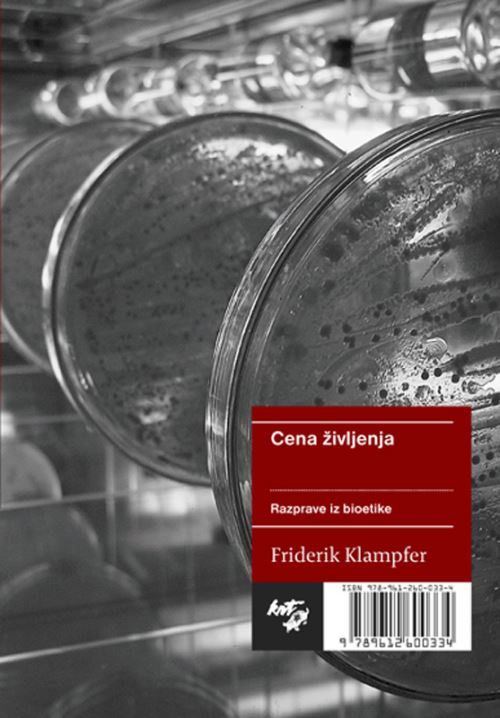

Podrobnosti o izdelku
Poglej vseISBN
9789612600334Mladinska knjiga ID
457050Leto izida
2010Velikost (šxdxv)
150 × 200 × 10Status dobavljivosti
Na zalogi pri dobaviteljuZbirka
163Jezik
SLOZaložnik
ZALOŽBA KRTINA, LJUBLJANAAvtor
FRIDERIK KLAMPFEROpis
Friderik Klampfer predava etiko, politično in socialno filozofijo na Filozofski fakulteti Univerze v Mariboru. Je avtor Etiškega pojmovnika za mlade (2003) in soavtor (z Janezom Bregantom in Smiljano Gartner) Telovadnice za možgane: uvoda v kritično mišljenje (2008) ter številnih člankov s področja teoretične in praktične etike ter politične filozofije.Pričujoča knjiga prinaša izbor iz avtorjevih dolgoletnih bolj ali manj sistematičnih razmišljanj o moralnih dilemah in vprašanjih, povezanih z ustvarjanjem, krojenjem in uničevanjem človeških (in nečloveških) življenj. Pričenja z obravnavo nekaterih dilemam, ki jih sprožajo nove metode spočetja in možnosti uporabe človeških zarodkov, in se zaključi z ugankami, ki nam jih zastavljajo smrt in čedalje večja možnost nadzora nad tem, kdaj in kako bomo umrli. Pristop in obravnava sta specifično filozofska, se pravi, da ju odlikuje pojmovna strogost, miselna disciplina in dovzetnost za razlikovanja. Pojmovnih, logičnih, metafizičnih in vrednostnih zagat avtor ne pometa pod preprogo, temveč kritično prevprašuje naše predfilozofske intuicije in druge samoumevnosti. Bioetika je vsaj pri nas v veliki meri še vedno talka zdravniškega, pravniškega in teološkega diskurza. Knjigo lahko zato razumemo kot poskus reafirmacije filozofske etike v bioetiki. Je dobrodošlo svarilo pred pomanjkljivostmi pristopa, ki v svoji slepoti za zapletene metafizične, pojmovne in vrednostne dileme in vprašanja bioetično razmišljanje in raziskovanje naivno razume, obravnava in prakticira kot v načelu priučljivo in vsakomur dostopno popoldansko, prostočasno dejavnost.
Pogosto kupljeno skupaj

Broširana
Ostali so si ogledali tudi ...


Več kot pol milijona knjig
Največja ponudba slovenskih in tujih knjig na enem mestu.

Enostaven nakup
Do izbranega le z nekaj kliki na spletu ali v eni od več kot 50 knjigarn.
Strokoven nasvet
Pred nakupom nas pokličite za nasvet ali se oglasite v knjigarni.

Vse za šolo
Nagrajena izobraževalna gradiva in kakovostne potrebščine.

Celovita ponudba za dom in pisarno
Vrhunski izdelki priznanih blagovnih znamk.
Brezplačna dostava
Brezplačna dostava za vsa naročila nad 59 € (za šolske pakete nad 140 €)
Knjigarne
Zaloga
×Osveženo 26.03.2023 10:09

Slovenska cesta 29, 1000 Ljubljana
E-naslovSpletna knjigarna: info@emka.si, Mladinska knjiga Založba: info@mladinska-knjiga.si
Kontakt01 241 30 00
Brezplačna številka080 12 05
Prijava na e-novice
© 2025 Mladinska knjiga. Vse pravice pridržane.
- Ko izberete elemente, se celotna stran osveži.
- Odpre se v novem oknu.